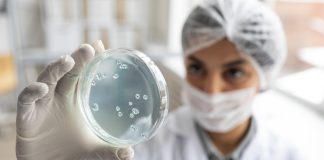
Brasil e França unem forças contra a RAM na COP-30 Brasil e França unem forças contra a RAM na COP-30

Tag: Ciencia
Brasil e França unem forças contra a RAM na COP-30
O evento “Resistência aos Antimicrobianos e Saúde Única” na COP-30 reforça a cooperação Brasil–França para enfrentar a RAM, debatendo impactos climáticos, diagnóstico laboratorial e a abordagem One Health. A programação reúne especialistas em painéis e mesa-redonda sobre riscos, soluções e cooperação internacional. A bioMérieux destaca a urgência de diagnósticos rápidos para conter a ameaça global.
Tattoo Week chega à 13ª edição com atrações musicais e pluralidade...
Em uma área de 22 mil metros quadrados e aberta a todas as idades, chega a São Paulo a 13ª Tattoo Week, nos dias 14, 15 e 16 de novembro, no Expo Center Norte, reunindo milhares de artistas e fãs da cultura tattoo, com destaque para os shows de Filipe Ret e MC Hariel
Tattoo Week chega à 13ª edição com atrações musicais e pluralidade...
Em uma área de 22 mil metros quadrados e aberta a todas as idades, chega a São Paulo a 13ª Tattoo Week, nos dias 14, 15 e 16 de novembro, no Expo Center Norte, reunindo milhares de artistas e fãs da cultura tattoo, com destaque para os shows de Filipe Ret e MC Hariel
SUS pode incorporar novo tratamento para doença renal
Sociedade pode contribuir para avaliação de tratamento que pode reduzir necessidade de diálise e aliviar pressão sobre o sistema público de saúde, segundo especialistas
Museu de Ciência amplia iniciativas sustentáveis na Amazônia
O Museu de Ciência da Amazônia (MuCA) integra ciência, cultura e empreendedorismo para transformar o futuro da floresta
Errata – Ponto de equilíbrio: por que ele decide o sucesso
O ponto de equilíbrio marca o momento em que a empresa cobre todos os seus custos, sem lucro ou prejuízo. Essencial para a sustentabilidade do negócio, ele orienta decisões estratégicas. A unidade da Farmácia Biomagistral em Belém atingiu esse marco em apenas dois meses — um feito notável, fruto de planejamento, estratégias da rede e atuação da franqueada Gizelle Vallinoto
Sete dicas para revisar com foco e chegar confiante no Enem
Especialista do Grupo Salta Educação ensina como aproveitar os últimos dias de preparação sem cair na armadilha do excesso
Evento The Future We Create promove encontros gratuitos
Após o evento The Future We Create, realizado em São Paulo em setembro de 2025, será inaugurada uma nova programação de encontros abertos voltados à reflexão sobre o futuro da sociedade. A iniciativa convida o público a integrar uma comunidade de pensamento regenerativo que busca transformar diálogo em ação, reunindo pessoas interessadas em temas como neurociência, saúde mental, sustentabilidade, educação e inovação empresarial e tecnológica
Festival de tecnologia e inovação movimenta São Carlos–SP
De 12 a 16 de novembro, São Carlos-SP, conhecida como a Capital Nacional da Tecnologia, sedia o São Carlos Experience 2025, um festival com centenas de eventos distribuídos pela cidade e foco em ciência, tecnologia, educação, empreendedorismo, cultura e qualidade de vida. A expectativa é de 10 mil participantes, mais de 200 palestrantes e área de exposição com dezenas de Startups.
Hackathon une IA e diversidade na educação inclusiva
Mais de 80 participantes de diferentes áreas colaboraram em uma maratona de ideias que resultou em projetos voltados a tornar a educação mais inclusiva, combinando criatividade humana e inteligência artificial